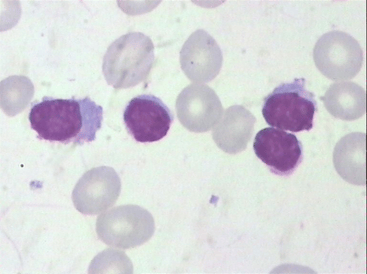
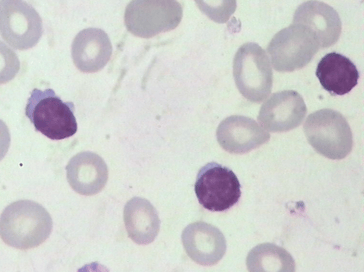
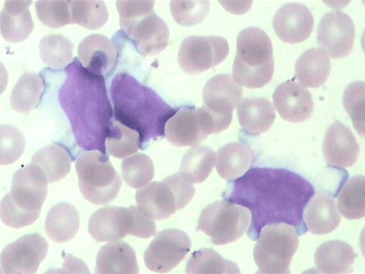
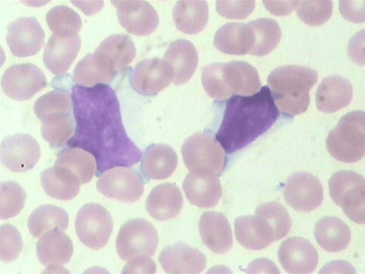

淋巴细胞增殖性疾病能活多久 淋巴细胞增殖性疾病治疗
淋巴细胞增殖性疾病能活多久 淋巴细胞增殖性疾病治疗

作者 | 马庆峰
单位 | 山东第一医科大学附属肥城医院(肥城市人民医院)
01前 言B细胞慢性淋巴增殖性疾病(B-CLPD)是临床上以外周血/骨髓成熟B细胞克隆性增殖为主要特征,并通过外周血/骨髓的形态学、免疫表型及细胞/分子遗传学检测可以诊断的一组成熟B淋巴增殖性疾病。包括原发白血病:慢性淋巴细胞白血病(CLL)、B-幼淋巴细胞白血病(B-PLL)、毛细胞白血病(HCL)、脾B细胞淋巴瘤/白血病,不能分类;淋巴瘤白血病期:边缘区淋巴瘤(MZL)、滤泡性淋巴瘤(FL)、套细胞淋巴瘤(MCL)、淋巴浆细胞淋巴瘤/华氏巨球蛋白血症(LPL/WM);B细胞慢性淋巴增殖性疾病,不能分类(B-CLPD-U)。02案例经过案例一:老年男性,因双下肢乏力半月就诊,血常规:

散点图:

其他检验结果:




案例二:老年男性,因血小板减少半月就诊,查体脾大。血常规:

散点图:

患者拒绝骨穿,服泼尼松2周后:


03案例分析案例一患者重度贫血,IgG升高,IgA、IgM降低。血清蛋白电泳、免疫固定电泳阳性,发现M蛋白条带,类型为IgG-κ型。尿本周蛋白电泳、尿蛋白电泳定量结果阴性。结合所有结果,高度怀疑为多发性骨髓瘤(MM)。送检骨髓涂片:增生活跃,成熟淋巴细胞占93%,成熟浆细胞1.5%。

骨髓活检:考虑B细胞淋巴瘤,建议MYD-88基因突变及其他检查综合除外淋巴浆细胞淋巴瘤可能。案例二患者血小板进行性下降,已到危急值,病情危重。白细胞总数、淋巴细胞比例继续升高,散点图在成熟淋巴细胞区域亮度明显增加,说明存在一群胞体大小、荧光强度非常相近的细胞。外周血涂片镜检成熟淋巴细胞73%,形态大部分如图:

形态类似单核细胞型异型淋巴细胞,不过如此高的比例,如是异淋,应三种形态都具备。结合老年人,形态特征一致,考虑其为单克隆性质,报告为不典型淋巴细胞。送检骨髓涂片:增生活跃,成熟淋巴细胞占48%。


流式:可见33%CD5阳性,CD10阴性成熟B淋巴细胞。骨髓活检:B细胞淋巴瘤/白血病。免疫组化:符合小B细胞淋巴瘤/白血病。染色体核型分析:46,(XY)。影像学:彩超可见双腋下、双腹股沟、腹腔内、双颈部淋巴结肿大。04知识拓展淋巴细胞总数>5×109/L,称为淋巴细胞增多症,可分为原发性淋巴细胞增多症和反应性淋巴细胞增多症。反应性淋巴细胞增多症多由病毒感染、应急反应、过敏反应等引起,原发性淋巴细胞增多症多为淋巴细胞恶性疾病。淋巴瘤和淋巴细胞白血病常同时存在,例如淋巴母细胞性淋巴瘤与急性淋巴细胞白血病、小淋巴细胞性淋巴瘤与慢性淋巴细胞性白血病均是同一肿瘤的不同临床表现。淋巴瘤和淋巴细胞白血病虽无本质区别,但二者临床表现不同,当存在广泛骨髓和外周血受累时诊断为白血病;当疾病表现为组织瘤块形成,不伴或仅有轻微血液和骨髓受累时诊断为淋巴瘤,但部分淋巴瘤在疾病后期会浸润骨髓形成淋巴瘤细胞白血病。05案例总结LPD因为是成熟淋巴细胞克隆性增殖,在白细胞总数不很高时容易被忽视。所以遇到老年患者,成熟淋巴细胞增高,或出现其他相关症状时,应考虑LPD可能。结合MICM综合诊断,更容易找到疾病本质,做到精准诊断与治疗。
【参考文献】
[1]B细胞慢性淋巴增殖性疾病诊断与鉴别诊断中国专家共识(2018)
[2]临床检验诊断学图谱/王建中主编.北京:人民卫生出版社,2012
[3]血液病诊断及疗效标准/沈悌赵永强主编.4版.北京:人民卫生出版社,2018
[4]临床血液学检验/许文荣王建中主编.5版.北京:人民卫生出版社,2012
-

- 长期应付款含税吗 长期应付款的税务风险
-
2024-01-29 19:05:13
-

- 令人怦然心动的文案长的 令人怦然心动的文案短句
-
2024-01-29 19:03:08
-

- 新增第5个直辖市设想:青岛、昆明、兰州、深圳,谁能笑到最后?
-
2024-01-29 19:01:03
-

- 手机来电话不响铃什么原因 手机来电话不显示怎么回事
-
2024-01-29 18:58:59
-

- 厦门交通发展规划 厦门交通发达
-
2024-01-29 18:56:54
-
- 铃木gw250摩托车(铃木gw250摩托车发动机是进口的吗)
-
2024-01-29 10:34:31
-
- 笔记本电脑打开后一直进不去界面怎么办(笔记本电脑打开后一直进不去界面怎么办
-
2024-01-29 10:32:26
-
- vivo系列档次排名x80和s16哪个好(vivo s10好还是vivo x60好)
-
2024-01-29 10:30:21
-

- m2003j15sc
-
2024-01-29 10:28:16
-

- 原神礼包兑换码大全最新(神灵契约的礼包兑换码)
-
2024-01-29 10:26:11
-
- b760m主板配什么cpu(华硕b760m主板配什么cpu)
-
2024-01-29 10:24:06
-

- 新换的华为手机电池怎么充电最好(华为手机换了新电池第一次怎么充电)
-
2024-01-29 10:22:01
-

- 荣耀60和50pro哪个值得买(荣耀50pro跟60pro谁更值得买)
-
2024-01-29 10:19:56
-

- 苹果xsmax触屏失灵一招解决(苹果xsmax屏幕卡死 无法强制关机)
-
2024-01-29 10:17:51
-
- 华为怎么退出开发者模式EMUI10(华为怎么关闭开发者模式10.0)
-
2024-01-29 10:15:46
-
- 联想笔记本哪个键按住是关机(windows11关机键怎么弄出来)
-
2024-01-29 07:22:16
-
- 充气气囊材料(充气气囊材料有哪几种)
-
2024-01-29 07:20:11
-
- 5g下载速度多少mbs(5g最快下载速度是多少兆)
-
2024-01-29 07:18:06
-
- 沃尔沃v60t5多少钱(2014款沃尔沃v60t5智雅版)
-
2024-01-29 07:16:01
-
- 雪佛兰camaro zl1(雪佛兰camaro ZL1跑车价格)
-
2024-01-29 07:13:56



 十大最有灵性的文玩 在文玩圈,要说有灵性,非这4种文玩莫属了!你认同吗?
十大最有灵性的文玩 在文玩圈,要说有灵性,非这4种文玩莫属了!你认同吗? 狗狗临死前的5个现象,它在跟你告别,主人都不忍心看到
狗狗临死前的5个现象,它在跟你告别,主人都不忍心看到